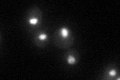
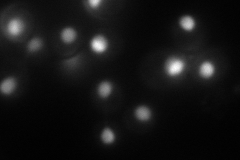
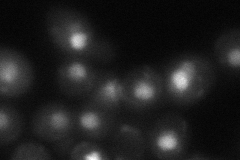
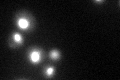

View description
Nucleosome remodeling factor that functions in regulation of transcription elongation; contains a chromo domain, a helicase domain and a DNA-binding domain; component of both the SAGA and SLIK complexes
Localization:
Intensity:
Fold change:
Significance:
-
C’ GFP library in SD
nucleus44.83 -
N' NOP1pr-GFP in SD
nucleus,nucleolus125.261 -
N' TEF2pr-mCherry in SD

nucleus96.8758 -
N' NATIVEpr-GFP in SD

nucleus43.0873 -
N' TEF2pr-VC and Cyto-VN in SD
nucleus55.0802 -
C’ GFP library in SD+DTT
nucleus37.280.83No -
C’ GFP library in SD+H2O2

nucleus44.830.99No -
C’ GFP library in Starvation Media

nucleus37.780.84No -
C’ GFP library on the background of Pup2-DaMP

nucleus -
C’ GFP library on the background of CCT mutant

nucleus47.941.06914No
